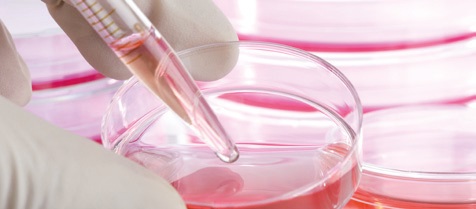

OBJECTIFS
– Différencier un bien d’un service.
– Différencier les notions d’emballage et de conditionnement.
– Découvrir les intervenants sur le marché de la coiffure.
1 – Distinction entre un bien et un service
Dans votre salon de coiffure, vous proposez à vos clients différents produits et services.
Un produit est un bien, c’est quelque chose de matériel (que l’on peut toucher). Il existe des biens « durables » que l’on peut utiliser longtemps, comme un fer à lisser, mais aussi des biens « non durables » qui se détruisent après utilisation ou qui périssent, comme une bouteille de shampooing.
Un service est une prestation immatérielle (que l’on ne peut pas toucher). Il existe des services marchands (que l’on vend), comme une coupe de cheveux chez le coiffeur, mais aussi des services non marchands (gratuits), comme l’école.
2 – L’emballage et le conditionnement
Afin de mettre en avant leurs produits, les fabricants investissent dans des emballages et des conditionnements de plus en plus attractifs pour les consommateurs.
EMBALLAGE
L’emballage est l’ensemble des éléments vendus avec le produit pour en assurer sa présentation, sa conservation ou son transport.
CONDITIONNEMENT
Le conditionnement est la première enveloppe en contact direct avec le produit.
3 – Les intervenants sur le marché de la coiffure
LE PRODUCTEUR
Le fabricant des produits.
LE GROSSISTE
Le marchand qui achète ses produits en très grande quantité aux producteurs afin de les revendre en plus petite quantité aux détaillants.
LE DÉTAILLANT
Le commerçant qui vend ses produits au détail – en petite quantité – aux consommateurs.
LE CONSOMMATEUR
La personne qui choisit, achète, et utilise un bien ou un service.
 Biblond, pour les coiffeurs !
Biblond, pour les coiffeurs !